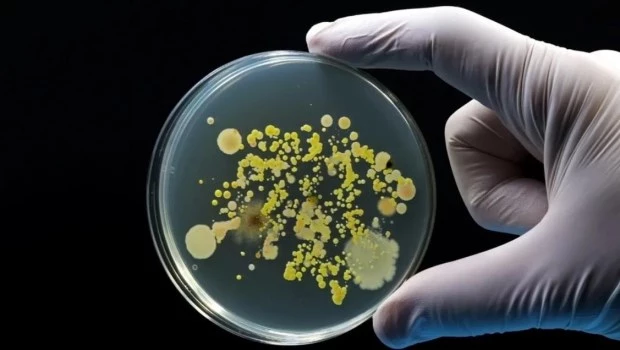
Brote de listeria en los Estados Unidos causa al menos 12 muertes

Brote de listeria en los Estados Unidos causa al menos 12 muertes
Los Ángeles, Estados Unidos - Al menos doce personas murieron en los Estados Unidos a raíz de un brote multiestatal de infecciones por listeria vinculado a batidos suplementarios, informaron los Centros para el Control y la Prevención de Enfermedades (CDC, por sus siglas en inglés).
Según los CDC, al menos 38 personas en 21 estados fueron infectadas, de las cuales 37 han requerido hospitalización. Muchas de las personas afectadas residían en centros de cuidados a largo plazo o estaban hospitalizadas antes de enfermarse.
Aunque algunos casos se remontan a 2018, más de la mitad de los afectados contrajeron la enfermedad entre 2024 y 2025. Es común que los brotes de listeria duren varios años, ya que se trata de una bacteria extremadamente resistente que puede sobrevivir en las superficies por períodos largos.
Los CDC señalaron que han investigado esta cepa varias veces, pero nunca contaron con suficiente información para identificar una fuente específica de alimentos, más allá de su presencia en centros de cuidados a largo plazo.
Sin embargo, continuaron, las pruebas ambientales y la secuenciación del genoma completo permitieron rastrear el origen del brote este año. Como medida de precaución, se han retirado del mercado todos los batidos suplementarios congelados de las marcas Lyons ReadyCare y Sysco Imperial dentro de su vida útil.
Estos productos fueron distribuidos en entornos institucionales, como establecimientos de cuidados a largo plazo.Los CDC instaron a la población a no consumir los productos retirados y a limpiar refrigeradores, recipientes y superficies que pudieran haber estado en contacto con ellos.
La listeria puede sobrevivir en el refrigerador y propagarse fácilmente a otros alimentos y superficies. Según los CDC, representa un alto riesgo para mujeres embarazadas, personas mayores de 65 años y personas con sistemas inmunitarios debilitados.